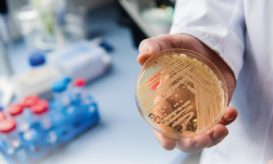
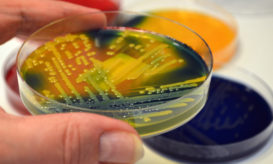

ECDC: Επικίνδυνος μύκητας εξαπλώνεται ραγδαία στα ελληνικά νοσοκομεία
Η Ελλάδα είναι μία από τις πέντε ευρωπαϊκές χώρες με τα περισσότερα κρούσματα στην ΕΕ.

Η Ελλάδα είναι μία από τις πέντε ευρωπαϊκές χώρες με τα περισσότερα κρούσματα στην ΕΕ.

Τι αναφέρει η καθηγήτρια Ελένη Γιαμαρέλλου. Τι προκαλεί στους ασθενείς που μολύνει και πως αντιμετωπίζεται.

Πρόκειται για τον μύκητα κάντιντα auris που προκαλεί σοβαρές λοιμώξεις στους νοσηλευόμενους ασθενείς.
Τι πρέπει να γνωρίζουμε για τον συγκεκριμένο μύκητα. Ποια είναι η προέλευσή του και γιατί ανησυχεί τους ειδικούς. Πως...
Ένας μύκητας που αποδεικνύεται πολύ ανθεκτικός στα αντιμυκητισιακά και ο οποίος μπορεί να σκοτώσει έναν ασθενή μέσα σε 90...